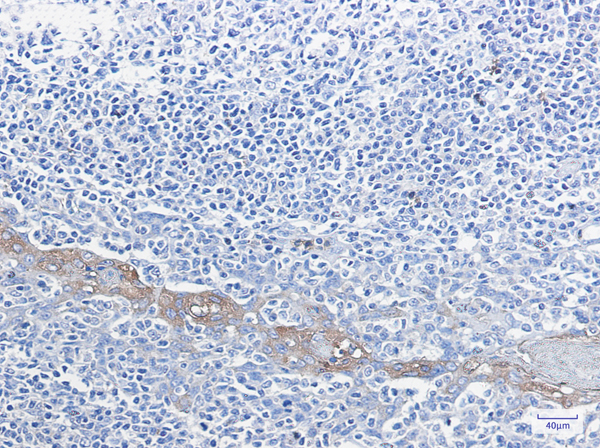
product-image-AAA314370_IHC13.jpg

Preparation and Storage
4 degree C
Related Product Information for OxiSelect Myeloperoxidase Activity assay kit
Principle of the Assay: The OxiSelect™ Myeloperoxidase Chlorination Activity Assay Kit is a quantitative assay for measuring the myeloperoxidase activity within a sample. The MPO enzyme catalyzes the reaction of hydrogen peroxide (H2O2) with chloride ions to create hypochlorous acid (HOCl), which rapidly reacts with taurine to produce a stable taurine chloramine product. This step readily neutralizes the HOCl, which would otherwise accumulate and inactivate MPO. A catalase-containing stop solution is added to stop MPO catalysis by eliminating hydrogen peroxide. Finally, taurine chloramine reacts with the yellow TNB chromogen probe, with a decrease in color indicating higher MPO activity (Figure 1). Absorbance is measured at 405-412 nm. The myeloperoxidase activity in unknown samples is determined by comparison with the predetermined TNB chromogen standard curve. The rate of chromophore reduction is proportional to the concentration of myeloperoxidase activity within the sample.
Background/Introduction: Myeloperoxidase (MPO) is a heme-based peroxidase enzyme responsible for antimicrobial activity against a wide range of organisms. MPO is copiously expressed in stimulated neutrophil granulocytes, where it catalyzes the production of hypoalous acids, such as hypochlorous acid (HOCl), from hydrogen peroxide (H2O2) and chloride ion (Cl-), or other halides. The characteristic heme green pigment of MPO can be seen in secretions containing neutrophils such as pus and mucus. Myeloperoxidase has been implicated in many disease states including arthritis, cancer, renal dysfunction, and cystic fibrosis. While myeloperoxidase deficiency is a hereditary disease that results in immune deficiency, antibodies against MPO have been linked to various types of vasculitis. The reactive species it creates may also damage normal tissues, thereby contributing to inflammation. An association of elevated MPO levels and coronary artery disease has been demonstrated and it has been reported that the enzyme could serve as a predictor of myocardial infarction in certain patients. The numerous roles MPO plays in the innate immune response and disease states make it a target for potential therapies. OxiSelect™ Myeloperoxidase Chlorination Activity Assay Kit is a quantitative assay for measuring myeloperoxidase activity within plasma, tissues, cell extracts, and purified samples. The assay is not species specific and should be well-suited to active MPO enzyme systems. Myeloperoxidase activity is defined as follows: 1 unit of enzyme reduces 1 umole hydrogen peroxide (H2O2) per minute at pH 6.0 and 25 degree C, and generates taurine chloramine to consume 1 umole of chromophore. Each kit provides sufficient reagents to perform up to 200 assays, including standard curve and unknown samples.
Background/Introduction: Myeloperoxidase (MPO) is a heme-based peroxidase enzyme responsible for antimicrobial activity against a wide range of organisms. MPO is copiously expressed in stimulated neutrophil granulocytes, where it catalyzes the production of hypoalous acids, such as hypochlorous acid (HOCl), from hydrogen peroxide (H2O2) and chloride ion (Cl-), or other halides. The characteristic heme green pigment of MPO can be seen in secretions containing neutrophils such as pus and mucus. Myeloperoxidase has been implicated in many disease states including arthritis, cancer, renal dysfunction, and cystic fibrosis. While myeloperoxidase deficiency is a hereditary disease that results in immune deficiency, antibodies against MPO have been linked to various types of vasculitis. The reactive species it creates may also damage normal tissues, thereby contributing to inflammation. An association of elevated MPO levels and coronary artery disease has been demonstrated and it has been reported that the enzyme could serve as a predictor of myocardial infarction in certain patients. The numerous roles MPO plays in the innate immune response and disease states make it a target for potential therapies. OxiSelect™ Myeloperoxidase Chlorination Activity Assay Kit is a quantitative assay for measuring myeloperoxidase activity within plasma, tissues, cell extracts, and purified samples. The assay is not species specific and should be well-suited to active MPO enzyme systems. Myeloperoxidase activity is defined as follows: 1 unit of enzyme reduces 1 umole hydrogen peroxide (H2O2) per minute at pH 6.0 and 25 degree C, and generates taurine chloramine to consume 1 umole of chromophore. Each kit provides sufficient reagents to perform up to 200 assays, including standard curve and unknown samples.
Product Categories/Family for OxiSelect Myeloperoxidase Activity assay kit
References
1. Kettle, A.J., et al. J. Clin. Invest. (1994) 233: 502-512.
2. Marquez, L. A., et al. J. Biol. Chem. (1994) 269: 7950-7956.
3. Nauseef, W. (2007) Isolation of Human Neutrophils From Venous Blood. In Neutrophil Methods and Protocols (Quinn M. T. et. al. eds.), Humana Press Totowa, NJ, 15-21.
4. Shih, J., et. al. Clin.Chem. (2008) 54: 1076-1079.
5. Weiss, S. J., et al. J. Clin. Invest. (1982) 70: 598-607.
2. Marquez, L. A., et al. J. Biol. Chem. (1994) 269: 7950-7956.
3. Nauseef, W. (2007) Isolation of Human Neutrophils From Venous Blood. In Neutrophil Methods and Protocols (Quinn M. T. et. al. eds.), Humana Press Totowa, NJ, 15-21.
4. Shih, J., et. al. Clin.Chem. (2008) 54: 1076-1079.
5. Weiss, S. J., et al. J. Clin. Invest. (1982) 70: 598-607.
Customer Reviews
Loading reviews...
Share Your Experience
Similar Products
Product Notes
The OxiSelect Myeloperoxidase Activity (Catalog #AAA44507) is an Assay Kit and is intended for research purposes only. The product is available for immediate purchase. It is sometimes possible for the material contained within the vial of "OxiSelect Myeloperoxidase Activity, Assay Kit" to become dispersed throughout the inside of the vial, particularly around the seal of said vial, during shipment and storage. We always suggest centrifuging these vials to consolidate all of the liquid away from the lid and to the bottom of the vial prior to opening. Please be advised that certain products may require dry ice for shipping and that, if this is the case, an additional dry ice fee may also be required.Precautions
All products in the AAA Biotech catalog are strictly for research-use only, and are absolutely not suitable for use in any sort of medical, therapeutic, prophylactic, in-vivo, or diagnostic capacity. By purchasing a product from AAA Biotech, you are explicitly certifying that said products will be properly tested and used in line with industry standard. AAA Biotech and its authorized distribution partners reserve the right to refuse to fulfill any order if we have any indication that a purchaser may be intending to use a product outside of our accepted criteria.Disclaimer
Though we do strive to guarantee the information represented in this datasheet, AAA Biotech cannot be held responsible for any oversights or imprecisions. AAA Biotech reserves the right to adjust any aspect of this datasheet at any time and without notice. It is the responsibility of the customer to inform AAA Biotech of any product performance issues observed or experienced within 30 days of receipt of said product. To see additional details on this or any of our other policies, please see our Terms & Conditions page.Item has been added to Shopping Cart
If you are ready to order, navigate to Shopping Cart and get ready to checkout.